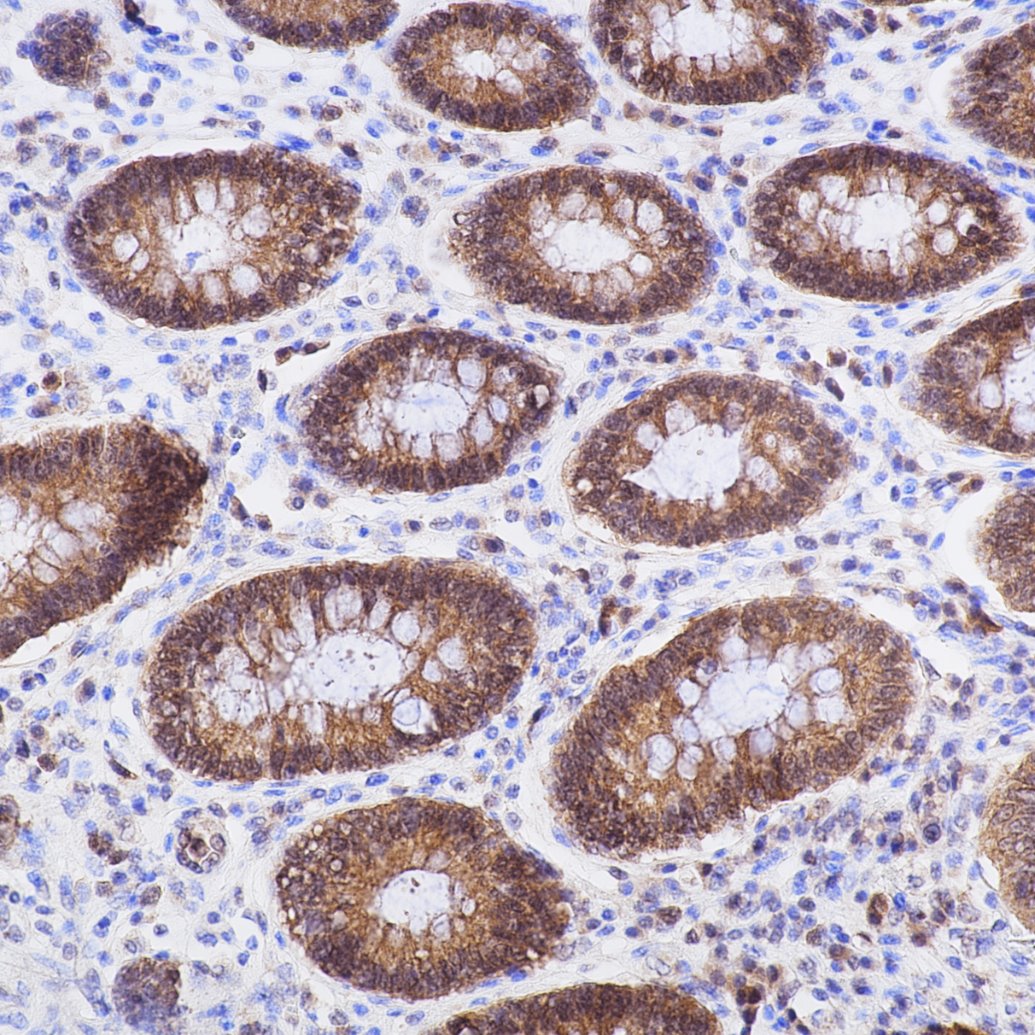
Immunohistochemistry (IHC) staining of human colon tissue using Caspase 3/P17/P19 Recombinant monoclonal antibody (82202-1-RR)

Tested Applications
| Positive WB detected in | Staurosporine treated Jurkat cells, HepG2 cells, HeLa cells, NIH/3T3 cells |
| Positive IHC-Autostainer detected in | human colon tissue |
| Positive IHC detected in | mouse brain tissue Note: suggested antigen retrieval with TE buffer pH 9.0; (*) Alternatively, antigen retrieval may be performed with citrate buffer pH 6.0 |
| Positive IF/ICC detected in | HeLa cells |
| Positive FC (Intra) detected in | HepG2 cells |
Recommended dilution
| Application | Dilution |
|---|---|
| Western Blot (WB) | WB : 1:5000-1:50000 |
| Immunohistochemistry (IHC)-AUTOSTAINER | IHC-AUTOSTAINER : 1:125-1:500 |
| Immunohistochemistry (IHC) | IHC : 1:250-1:1000 |
| Immunofluorescence (IF)/ICC | IF/ICC : 1:500-1:2000 |
| Flow Cytometry (FC) (INTRA) | FC (INTRA) : 0.40 ug per 10^6 cells in a 100 µl suspension |
| It is recommended that this reagent should be titrated in each testing system to obtain optimal results. | |
| Sample-dependent, Check data in validation data gallery. | |
Published Applications
| WB | See 45 publications below |
| IHC | See 8 publications below |
| IF | See 5 publications below |
Product Information
82202-1-RR targets Caspase 3/P17/P19 in WB, IHC, IHC-Autostainer, IF/ICC, FC (Intra), ELISA applications and shows reactivity with human, mouse samples.
| Tested Reactivity | human, mouse |
| Cited Reactivity | human, mouse, rat, rabbit, bovine |
| Host / Isotype | Rabbit / IgG |
| Class | Recombinant |
| Type | Antibody |
| Immunogen |
Peptide Predict reactive species |
| Full Name | caspase 3, apoptosis-related cysteine peptidase |
| Calculated Molecular Weight | 32 kDa |
| Observed Molecular Weight | 32-35 kDa, 17 kDa, 19 kDa |
| GenBank Accession Number | NM_004346 |
| Gene Symbol | Caspase 3 |
| Gene ID (NCBI) | 836 |
| RRID | AB_3086469 |
| Conjugate | Unconjugated |
| Form | Liquid |
| Purification Method | Protein A purification |
| UNIPROT ID | P42574 |
| Storage Buffer | PBS with 0.02% sodium azide and 50% glycerol, pH 7.3. |
| Storage Conditions | Store at -20°C. Stable for one year after shipment. Aliquoting is unnecessary for -20oC storage. 20ul sizes contain 0.1% BSA. |
Background Information
Caspases, a family of endoproteases, are critical players in cell regulatory networks controlling inflammation and cell death. Initiator caspases (caspase-2, -8, -9, -10, -11, and -12) cleave and activate downstream effector caspases (caspase-3, -6, and -7), which in turn execute apoptosis by cleaving targeted cellular proteins. Caspase 3 (also named CPP32, SCA-1, and Apopain) proteolytically cleaves poly(ADP-ribose) polymerase (PARP) at the beginning of apoptosis. Caspase 3 plays a key role in the activation of sterol regulatory element binding proteins (SREBPs) between the basic helix-loop-helix leucine zipper domain and the membrane attachment domain. Caspase 3 can also form heterocomplex with other proteins and performs the molecular mass of 50-70 kDa. This antibody can recognize p17, p19 and p32 of Caspase 3.
Protocols
| Product Specific Protocols | |
|---|---|
| FC protocol for Caspase 3/P17/P19 antibody 82202-1-RR | Download protocol |
| IF protocol for Caspase 3/P17/P19 antibody 82202-1-RR | Download protocol |
| IHC protocol for Caspase 3/P17/P19 antibody 82202-1-RR | Download protocol |
| WB protocol for Caspase 3/P17/P19 antibody 82202-1-RR | Download protocol |
| Standard Protocols | |
|---|---|
| Click here to view our Standard Protocols |
Publications
| Species | Application | Title |
|---|---|---|
Acta Pharm Sin B Design, synthesis, and antitumor activity of novel thioheterocyclic nucleoside derivatives by suppressing the c-MYC pathway | ||
Biomaterials Hydrogen-releasing electroactive nerve guidance conduits promote peripheral nerve regeneration by remodeling the microenvironment | ||
Int Immunopharmacol CSF1R inhibition agents protect against cisplatin ototoxicity and synergize with immunotherapy for Head and Neck Squamous Cell Carcinoma | ||
Acta Biochim Biophys Sin (Shanghai) Magnolol promotes the autophagy of esophageal carcinoma cells by upregulating HACE1 gene expression | ||
BMC Complement Med Ther Isorhamnetin protects against D-GalN/LPS-induced acute liver injury in mice through anti-oxidative stress, anti-inflammation, and anti-apoptosis | ||
Ecotoxicol Environ Saf Multi-omics analysis explore the mechanism of deoxynivalenol inhibiting rabbit appetite through microbial-gut-brain axis |